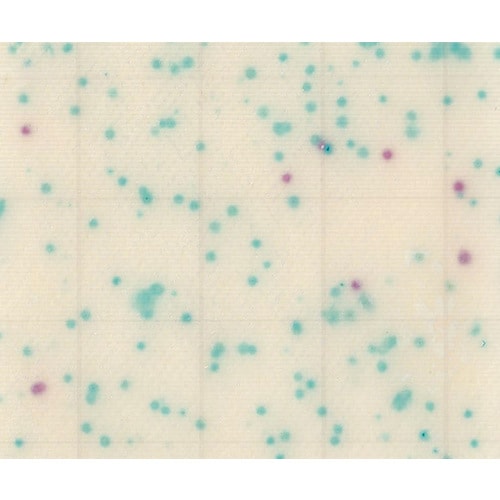
【冷蔵】MCMediaPad 大腸菌・大腸菌群用

JNC
MC−Media Pad EC 大腸菌・大腸菌群用 (1000枚) 2−5838−77 培地 簡易培地 1ケース(100枚入×10)
【4622-8543】



3/2(月)〜 3/31(火)
| ¥119,130 (税込) / ¥108,300 (税抜) |
| ¥119,130 (税込) / ¥108,300 (税抜) |
| メーカー希望小売価格※税抜 (割引率) ¥120,000(9%) |
|---|
培地関連用品の売れ筋ランキング
- ¥6,030(税込) (税込)
- ¥3,135(税込) (税込)
- ¥2,090(税込) (税込)
商品の特徴 |
手軽かつ正確な微生物検査ができます。食材等の試料液検査をはじめスタンプ法・塗抹法・メンブレンフィルター法・落下菌の検査ができます。長時間保存が可能で、かさばりません。国際認証機関 MicroVal、AOAC PTM 認証を取得しています。 |
|---|---|
商品仕様 |
|
メーカー情報 |
|
カタログ掲載ページ |
-/- |
| 注意事項 | ※この商品は貯蔵または配送の際に冷蔵が必要な商品です。 |
|---|